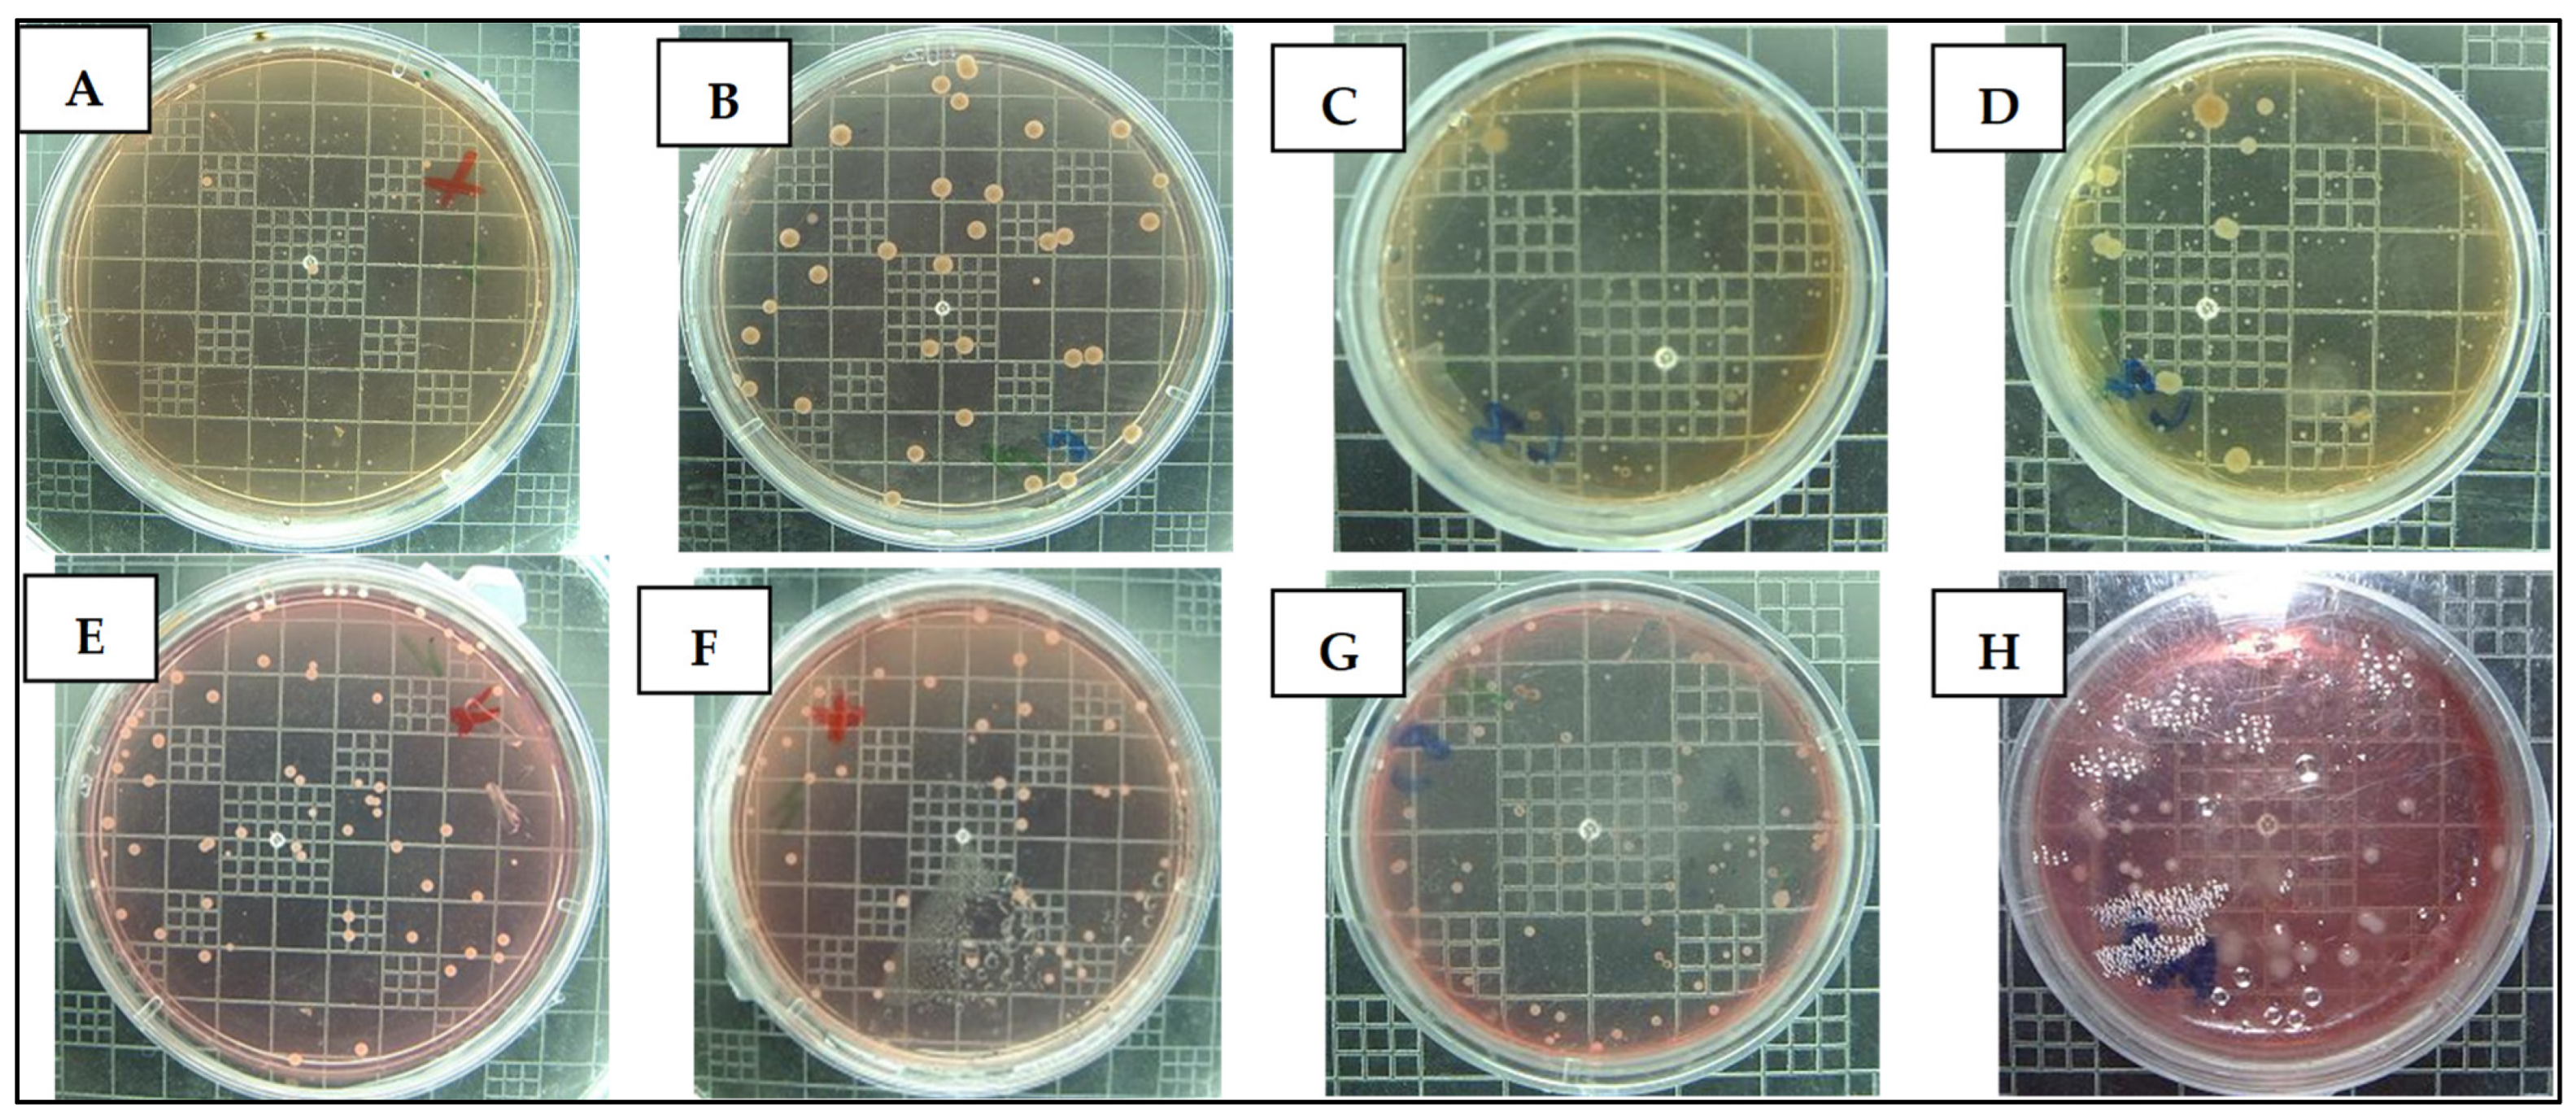
Fermentation 11 00100 g006

Diluted Acid Hydrolysate of Olive Stones: Overliming and Biomass Fermentation
Abstract
1. Introduction
2. Materials and Methods
2.1. Raw Material
2.2. Dilute-Acid Hydrolysate (DAH) Preparation and Titration
2.3. Experimental Design
2.4. Detoxifications of Hydrolysate
2.5. Yeast Strain Maintaining
2.6. Inoculums Culture
2.7. Culture Conditions
2.8. Analytical Methods
3. Results
3.1. Hydrolysate Composition
3.2. Titration of the Hydrolysate
3.3. Detoxification of Hydrolysates Evolution
3.4. Yeasts Vitality and Viability
4. Discussion
5. Conclusions
Supplementary Materials
Author Contributions
Funding
Institutional Review Board Statement
Informed Consent Statement
Data Availability Statement
Acknowledgments
Conflicts of Interest
References
- El Chami, A.; Conte, P.; Hassoun, G.; Piga, A. Effect of Region of Cultivation, Tree Age, and Harvest Time on the Quality of Lebanese Virgin Olive Oil. Ital. J. Food Sci. 2023, 35, 57–71. [Google Scholar] [CrossRef]
- Chehade, A.; Bitar, A.E.; Kadri, A.; Choueiri, E.; Nabbout, R.; Youssef, H.; Smeha, M.; Awada, A.; Chami, Z.A.; Dubla, E.; et al. In Situ Evaluation of the Fruit and Oil Characteristics of the Main Lebanese Olive Germplasm. J. Sci. Food Agric. 2016, 96, 2532–2538. [Google Scholar] [CrossRef] [PubMed]
- Hassen, W.; Hassen, B.; Werhani, R.; Hidri, Y.; Jedidi, N.; Hassen, A. Processes of Valorization and Management of Olive By-Products: The Pomace and Olive Mill Wastewater. In Wastewater from Olive Oil Production; Souabi, S., Anouzla, A., Eds.; Springer Water; Springer International Publishing: Cham, Switzerland, 2023; pp. 1–25. ISBN 978-3-031-23448-4. [Google Scholar]
- Blasi, A.; Verardi, A.; Lopresto, C.G.; Siciliano, S.; Sangiorgio, P. Lignocellulosic Agricultural Waste Valorization to Obtain Valuable Products: An Overview. Recycling 2023, 8, 61. [Google Scholar] [CrossRef]
- Dunne, G. Transforming Olive Waste into Animal Feed. Int. J. Clin. Nutr. Diet. 2019, 5, 142. [Google Scholar] [CrossRef]
- Molina-Alcaide, E.; Yáñez-Ruiz, D.R. Potential Use of Olive By-Products in Ruminant Feeding: A Review. Anim. Feed. Sci. Technol. 2008, 147, 247–264. [Google Scholar] [CrossRef]
- Sansoucy, R.; Alibes, X.; Berge, P. Olive By-Products for Animal Feed; FAO Animal Production and Health Paper; Food and Agriculture Organization of the United Nations: Rome, Italy, 1985; ISBN 978-92-5-101488-2. [Google Scholar]
- Cuevas, M.; García Martín, J.F.; Bravo, V.; Sánchez, S. Ethanol Production from Olive Stones through Liquid Hot Water Pre-Treatment, Enzymatic Hydrolysis and Fermentation. Influence of Enzyme Loading, and Pre-Treatment Temperature and Time. Fermentation 2021, 7, 25. [Google Scholar] [CrossRef]
- Mussatto, S. Alternatives for Detoxification of Diluted-Acid Lignocellulosic Hydrolyzates for Use in Fermentative Processes: A Review. Bioresour. Technol. 2004, 93, 1–10. [Google Scholar] [CrossRef]
- Wyman, C.; Decker, S.; Himmel, M.; Brady, J.; Skopec, C.; Viikari, L. Hydrolysis of Cellulose and Hemicellulose. In Polysaccharides; Dumitriu, S., Ed.; CRC Press: Boca Raton, FL, USA, 2004; ISBN 978-0-8247-5480-8. [Google Scholar]
- Houfani, A.A.; Anders, N.; Spiess, A.C.; Baldrian, P.; Benallaoua, S. Insights from Enzymatic Degradation of Cellulose and Hemicellulose to Fermentable Sugars—A Review. Biomass Bioenergy 2020, 134, 105481. [Google Scholar] [CrossRef]
- Świątek, K.; Gaag, S.; Klier, A.; Kruse, A.; Sauer, J.; Steinbach, D. Acid Hydrolysis of Lignocellulosic Biomass: Sugars and Furfurals Formation. Catalysts 2020, 10, 437. [Google Scholar] [CrossRef]
- Palmqvist, E.; Hahn-Hägerdal, B. Fermentation of Lignocellulosic Hydrolysates. I: Inhibition and Detoxification. Bioresour. Technol. 2000, 74, 17–24. [Google Scholar] [CrossRef]
- Palmqvist, E.; Hahn-Hägerdal, B. Fermentation of Lignocellulosic Hydrolysates. II: Inhibitors and Mechanisms of Inhibition. Bioresour. Technol. 2000, 74, 25–33. [Google Scholar] [CrossRef]
- Andary, J.; Maalouly, J.; Ouaini, R.; Chebib, H.; Rutledge, D.N.; Ouaini, N. Application of 2D Correlation Spectroscopy on Olive Stones Acid Hydrolysates: Effect of Overliming. Chemom. Intell. Lab. Syst. 2012, 113, 58–67. [Google Scholar] [CrossRef]
- Andary, J.; Maalouly, J.; Ouain, R.; Chebib, H.; Beyrouthy, M.; Rutledge, D.N.; Ouaini, N. Phenolic Compounds from Diluted Acid Hydrolysates of Olive Stones: Effect of Overliming. Adv. Crop. Sci.Tech. 2013, 1, 103. [Google Scholar] [CrossRef]
- Negritto, M.C.; Valdez, C.; Sharma, J.; Rosenberg, C.; Selassie, C.R. Growth Inhibition and DNA Damage Induced by X-Phenols in Yeast: A Quantitative Structure—Activity Relationship Study. ACS Omega 2017, 2, 8568–8579. [Google Scholar] [CrossRef] [PubMed]
- Chen, X.; Zhai, R.; Li, Y.; Yuan, X.; Liu, Z.-H.; Jin, M. Understanding the Structural Characteristics of Water-Soluble Phenolic Compounds from Four Pretreatments of Corn Stover and Their Inhibitory Effects on Enzymatic Hydrolysis and Fermentation. Biotechnol. Biofuels 2020, 13, 44. [Google Scholar] [CrossRef]
- Furia, E.; Beneduci, A.; Malacaria, L.; Fazio, A.; La Torre, C.; Plastina, P. Modeling the Solubility of Phenolic Acids in Aqueous Media at 37 °C. Molecules 2021, 26, 6500. [Google Scholar] [CrossRef] [PubMed]
- Purwadi, R.; Niklasson, C.; Taherzadeh, M.J. Kinetic Study of Detoxification of Dilute-Acid Hydrolyzates by Ca(OH)2. J. Biotechnol. 2004, 114, 187–198. [Google Scholar] [CrossRef]
- Chheda, J.N.; Román-Leshkov, Y.; Dumesic, J.A. Production of 5-Hydroxymethylfurfural and Furfural by Dehydration of Biomass-Derived Mono- and Poly-Saccharides. Green. Chem. 2007, 9, 342–350. [Google Scholar] [CrossRef]
- Andary, J.; Maalouly, J.; Ouaini, R.; Chebib, H.; Rutledge, D.N.; Ouaini, N. Stability Study of Furans, Glucose and Xylose under Overliming Conditions: Effect of Sugar Degradation Products. Bioresour. Technol. Rep. 2021, 15, 100722. [Google Scholar] [CrossRef]
- Hu, L.; He, A.; Liu, X.; Xia, J.; Xu, J.; Zhou, S.; Xu, J. Biocatalytic Transformation of 5-Hydroxymethylfurfural into High-Value Derivatives: Recent Advances and Future Aspects. ACS Sustain. Chem. Eng. 2018, 6, 15915–15935. [Google Scholar] [CrossRef]
- Quéméneur, M.; Hamelin, J.; Barakat, A.; Steyer, J.-P.; Carrère, H.; Trably, E. Inhibition of Fermentative Hydrogen Production by Lignocellulose-Derived Compounds in Mixed Cultures. Int. J. Hydrogen Energy 2012, 37, 3150–3159. [Google Scholar] [CrossRef]
- Heer, D.; Sauer, U. Identification of Furfural as a Key Toxin in Lignocellulosic Hydrolysates and Evolution of a Tolerant Yeast Strain. Microb. Biotechnol. 2008, 1, 497–506. [Google Scholar] [CrossRef] [PubMed]
- Zheng, Z.; Xu, Q.; Tan, H.; Zhou, F.; Ouyang, J. Selective Biosynthesis of Furoic Acid from Furfural by Pseudomonas Putida and Identification of Molybdate Transporter Involvement in Furfural Oxidation. Front. Chem. 2020, 8, 587456. [Google Scholar] [CrossRef]
- Taherzadeh, M.J.; Niklasson, C.; Lidén, G. On-Line Control of Fed-Batch Fermentation of Dilute-Acid Hydrolyzates. Biotechnol. Bioeng. 2000, 69, 330–338. [Google Scholar] [CrossRef] [PubMed]
- Iwaki, A.; Kawai, T.; Yamamoto, Y.; Izawa, S. Biomass Conversion Inhibitors Furfural and 5-Hydroxymethylfurfural Induce Formation of Messenger RNP Granules and Attenuate Translation Activity in Saccharomyces Cerevisiae. Appl. Environ. Microbiol. 2013, 79, 1661–1667. [Google Scholar] [CrossRef] [PubMed]
- Ujor, V.C.; Okonkwo, C.C. Microbial Detoxification of Lignocellulosic Biomass Hydrolysates: Biochemical and Molecular Aspects, Challenges, Exploits and Future Perspectives. Front. Bioeng. Biotechnol. 2022, 10, 1061667. [Google Scholar] [CrossRef] [PubMed]
- Mateo, S.; Roberto, I.C.; Sánchez, S.; Moya, A.J. Detoxification of Hemicellulosic Hydrolyzate from Olive Tree Pruning Residue. Ind. Crops Prod. 2013, 49, 196–203. [Google Scholar] [CrossRef]
- Millati, R.; Niklasson, C.; Taherzadeh, M.J. Effect of pH, Time and Temperature of Overliming on Detoxification of Dilute-Acid Hydrolyzates for Fermentation by Saccharomyces Cerevisiae. Process Biochem. 2002, 38, 515–522. [Google Scholar] [CrossRef]
- Martinez, A.; Rodriguez, M.E.; Wells, M.L.; York, S.W.; Preston, J.F.; Ingram, L.O. Detoxification of Dilute Acid Hydrolysates of Lignocellulose with Lime. Biotechnol. Progress. 2001, 17, 287–293. [Google Scholar] [CrossRef]
- Martin, G.J.O.; Chan, S. Future Production of Yeast Biomass for Sustainable Proteins: A Critical Review. Sustain. Food Technol. 2024, 2, 1592–1609. [Google Scholar] [CrossRef]
- Bakare, V.; Abdulsalami, M.S.; Onusiriuka, B.C.; Appah, J.; Benjamin, B.; Ndibe, T.O. Ethanol Production from Lignocellulosic Materials by Fermentation Process Using Yeast. J. Appl. Sci. Environ. Manag. 2019, 23, 875. [Google Scholar] [CrossRef]
- Tsegaye, K.N.; Alemnew, M.; Berhane, N. Saccharomyces Cerevisiae for Lignocellulosic Ethanol Production: A Look at Key Attributes and Genome Shuffling. Front. Bioeng. Biotechnol. 2024, 12, 1466644. [Google Scholar] [CrossRef] [PubMed]
- Moysés, D.; Reis, V.; Almeida, J.; Moraes, L.; Torres, F. Xylose Fermentation by Saccharomyces Cerevisiae: Challenges and Prospects. Int. J. Mol. Sci. 2016, 17, 207. [Google Scholar] [CrossRef]
- Qiu, Y.; Wu, M.; Bao, H.; Liu, W.; Shen, Y. Engineering of Saccharomyces Cerevisiae for Co-Fermentation of Glucose and Xylose: Current State and Perspectives. Eng. Microbiol. 2023, 3, 100084. [Google Scholar] [CrossRef] [PubMed]
- Abomohra, A.E.; Wang, Q.; Huang, J.; Saad-Allah, K.M. A Sustainable Approach for Bioconversion of Food and Lignocellulosic Wastes into Liquid Biofuel Using a New Metschnikowia pulcherrima Isolate. Int. J. Energy Res. 2021, 45, 3430–3441. [Google Scholar] [CrossRef]
- Fan, J.; Santomauro, F.; Budarin, V.L.; Whiffin, F.; Abeln, F.; Chantasuban, T.; Gore-Lloyd, D.; Henk, D.; Scott, R.J.; Clark, J.; et al. The Additive Free Microwave Hydrolysis of Lignocellulosic Biomass for Fermentation to High Value Products. J. Clean. Prod. 2018, 198, 776–784. [Google Scholar] [CrossRef]
- Michou, S.; Tsouko, E.; Vastaroucha, E.-S.; Diamantopoulou, P.; Papanikolaou, S. Growth Potential of Selected Yeast Strains Cultivated on Xylose-Based Media Mimicking Lignocellulosic Wastewater Streams: High Production of Microbial Lipids by Rhodosporidium Toruloides. Fermentation 2022, 8, 713. [Google Scholar] [CrossRef]
- Romero-García, J.M.; Fehér, C.; Cara, C.; Ruiz-Ramos, E.; Castro, E. Improved Xylitol Production from Olive Stones Hydrolysates by Biological Detoxification. J. Clean. Prod. 2022, 336, 130408. [Google Scholar] [CrossRef]
- Santamauro, F.; Whiffin, F.M.; Scott, R.J.; Chuck, C.J. Low-Cost Lipid Production by an Oleaginous Yeast Cultured in Non-Sterile Conditions Using Model Waste Resources. Biotechnol. Biofuels 2014, 7, 34. [Google Scholar] [CrossRef] [PubMed]
- Lewis, G.A.; Mathieu, D.; Phan-Tan-Luu, R. Pharmaceutical Experimental Design; CRC Press: Boca Raton, FL, USA, 1998; ISBN 978-0-203-50868-8. [Google Scholar]
- Green, S.R.; Moehle, C.M. Media and Culture of Yeast. CP Cell Biol. 1999, 4, 1–6. [Google Scholar] [CrossRef] [PubMed]
- Doppler, F.; Jelonkiewicz, L.; Rezaei, M.N.; Lesens, C.; Toussaint, R.; Durand-Dubief, M. Viability of Saccharomyces Cerevisiae during Baking of Bread Dough by Flow Cytometry. J. Microbiol. Methods 2022, 200, 106556. [Google Scholar] [CrossRef]
- Godshall, M.A. Sugar, Sugar Analysis. In Kirk-Othmer Encyclopedia of Chemical Technology; Raymond Eller Kirk, Donald Frederick Othmer, Ed.; Wiley: Hoboken, NJ, USA, 2000; ISBN 978-0-471-48494-3. [Google Scholar]
- Jönsson, L.J.; Alriksson, B.; Nilvebrant, N.-O. Bioconversion of Lignocellulose: Inhibitors and Detoxification. Biotechnol. Biofuels 2013, 10, 16. [Google Scholar] [CrossRef] [PubMed]
- Guo, X.; Cavka, A.; Jönsson, L.J.; Hong, F. Comparison of Methods for Detoxification of Spruce Hydrolysate for Bacterial Cellulose Production. Microb. Cell Fact. 2013, 12, 93. [Google Scholar] [CrossRef] [PubMed]
- Ranatunga, T.D.; Jervis, J.; Helm, R.F.; McMillan, J.D.; Wooley, R.J. The Effect of Overliming on the Toxicity of Dilute Acid Pretreated Lignocellulosics: The Role of Inorganics, Uronic Acids and Ether-Soluble Organics. Enzym. Microb. Technol. 2000, 27, 240–247. [Google Scholar] [CrossRef] [PubMed]
- Cantarella, M.; Cantarella, L.; Gallifuoco, A.; Spera, A.; Alfani, F. Comparison of Different Detoxification Methods for Steam-Exploded Poplar Wood as a Substrate for the Bioproduction of Ethanol in SHF and SSF. Process Biochem. 2004, 39, 1533–1542. [Google Scholar] [CrossRef]
- Zhang, K.; Wells, P.; Liang, Y.; Love, J.; Parker, D.A.; Botella, C. Effect of Diluted Hydrolysate as Yeast Propagation Medium on Ethanol Production. Bioresour. Technol. 2019, 271, 1–8. [Google Scholar] [CrossRef]
- Mohagheghi, A.; Ruth, M.; Schell, D.J. Conditioning Hemicellulose Hydrolysates for Fermentation: Effects of Overliming pH on Sugar and Ethanol Yields. Process Biochem. 2006, 41, 1806–1811. [Google Scholar] [CrossRef]
- Forssk»hl, I.; Popoff, T.; Theander, O. Reactions of D-Xylose and D-Glucose in Alkaline, Aqueous Solutions. Carbohydr. Res. 1976, 48, 13–21. [Google Scholar] [CrossRef]
- Yang, B.Y.; Montgomery, R. Alkaline Degradation of Glucose: Effect of Initial Concentration of Reactants. Carbohydr. Res. 1996, 280, 27–45. [Google Scholar] [CrossRef]
- Russell, J.A.; Miller, R.K.; Molton, P.M. Formation of Aromatic Compounds from Condensation Reactions of Cellulose Degradation Products. Biomass 1983, 3, 43–57. [Google Scholar] [CrossRef]
- Daza-Serna, L.; Masi, A.; Serna-Loaiza, S.; Pfnier, J.; Stark, G.; Mach, R.L.; Mach-Aigner, A.R.; Friedl, A. Detoxification Strategy of Wheat Straw Hemicellulosic Hydrolysate for Cultivating Trichoderma Reesei: A Contribution towards the Wheat Straw Biorefinery. Biomass Conv. Bioref. 2023, 13, 16495–16509. [Google Scholar] [CrossRef]
- Almeida, J.R.; Modig, T.; Petersson, A.; Hähn-Hägerdal, B.; Lidén, G.; Gorwa-Grauslund, M.F. Increased Tolerance and Conversion of Inhibitors in Lignocellulosic Hydrolysates bySaccharomyces Cerevisiae. J. Chem. Technol. Biotechnol. 2007, 82, 340–349. [Google Scholar] [CrossRef]
- Li, B.; Liu, N.; Zhao, X. Response Mechanisms of Saccharomyces Cerevisiae to the Stress Factors Present in Lignocellulose Hydrolysate and Strategies for Constructing Robust Strains. Biotechnol. Biofuels 2022, 15, 28. [Google Scholar] [CrossRef] [PubMed]
- Bellissimi, E.; Van Dijken, J.P.; Pronk, J.T.; Van Maris, A.J.A. Effects of Acetic Acid on the Kinetics of Xylose Fermentation by an Engineered, Xylose-Isomerase-Based Saccharomyces Cerevisiae Strain. FEMS Yeast Res. 2009, 9, 358–364. [Google Scholar] [CrossRef] [PubMed]

| pH | Ca(OH)2 g·L−1 | Temperature (°C) | Time min | D-Xylose | HMF | FF | PP | S. cerevisiae Viability | M. pulcherrima Viability | ||||||||
|---|---|---|---|---|---|---|---|---|---|---|---|---|---|---|---|---|---|
| g·L−1 | stdv | mg·L−1 | stdv | mg·L−1 | stdv | mg·L−1 | stdv | TCA Glucose | stdv | TCA Glucose | stdv | TCA Xylose | stdv | ||||
| 0.32 | Hydrolysate | - | 9.615 | 0.120 | 184.700 | 0.141 | 80.475 | 1.167 | 1249.005 | 7.955 | 2.200 | 0.707 | 10.850 | 1.768 | 20.350 | 3.323 | |
| 10 | 77.5 | 25 | 15 | 7.480 | 0.453 | 98.805 | 7.460 | 51.650 | 0.566 | 684.005 | 16.794 | 61.433 | 4.332 | 17.000 | 9.224 | 41.650 | 2.333 |
| 30 | 4.935 | 0.085 | 53.625 | 3.288 | 30.720 | 0.311 | 579.630 | 8.839 | 67.000 | 1.179 | 27.400 | 1.039 | 51.650 | 2.333 | |||
| 60 | 4.850 | 0.127 | 37.385 | 0.785 | 22.650 | 1.061 | 698.380 | 30.052 | 76.233 | 2.248 | 25.967 | 0.737 | 48.650 | 1.909 | |||
| 60 | 15. | 5.780 | 0.085 | 83.405 | 1.365 | 49.640 | 0.792 | 975.880 | 26.517 | 58.233 | 7.607 | 23.800 | 0.173 | 44.350 | 0.495 | ||
| 30 | 5.390 | 0.085 | 66.325 | 0.771 | 43.180 | 0.453 | 737.755 | 2.652 | 72.900 | 10.701 | 25.467 | 1.172 | 48.350 | 2.333 | |||
| 60 | 4.075 | 0.247 | 45.145 | 1.690 | 20.510 | 1.004 | 1099.630 | 8.839 | 68.000 | 5.522 | 24.067 | 5.534 | 50.650 | 3.748 | |||
| 12 | 85 | 25 | 15 | 5.540 | 0.396 | 48.660 | 0.028 | 26.105 | 0.064 | 471.505 | 4.419 | 77.100 | 19.507 | 22.133 | 2.926 | 44.350 | 2.333 |
| 30 | 5.005 | 0.163 | 27.145 | 0.290 | 10.830 | 0.085 | 627.130 | 8.839 | 56.433 | 5.363 | 21.433 | 3.139 | 37.650 | 6.152 | |||
| 60 | 4.600 | 0.014 | 22.045 | 0.559 | 6.360 | 0.057 | 702.130 | 26.517 | 51.867 | 3.156 | 23.667 | 3.225 | 41.000 | 3.253 | |||
| 60 | 15 | 5.630 | 0.297 | 9.165 | 1.039 | 6.580 | 0.764 | 870.255 | 9.723 | 61.433 | 8.771 | 24.533 | 8.358 | 44.000 | 14.637 | ||
| 30 | 2.875 | 0.021 | 7.410 | 0.226 | 4.215 | 0.078 | 915.255 | 7.955 | 49.333 | 9.018 | 9.267 | 5.670 | 19.300 | 14.142 | |||
| 60 | 1.985 | 0.035 | 5.335 | 0.530 | 3.360 | 0.523 | 970.880 | 3.536 | 27.800 | 2.707 | 19.767 | 1.457 | 35.350 | 0.919 | |||
Disclaimer/Publisher’s Note: The statements, opinions and data contained in all publications are solely those of the individual author(s) and contributor(s) and not of MDPI and/or the editor(s). MDPI and/or the editor(s) disclaim responsibility for any injury to people or property resulting from any ideas, methods, instructions or products referred to in the content. |
© 2025 by the authors. Licensee MDPI, Basel, Switzerland. This article is an open access article distributed under the terms and conditions of the Creative Commons Attribution (CC BY) license (https://creativecommons.org/licenses/by/4.0/).
Share and Cite
Andary, J.; Ouaini, N.; Abou-Khalil, R. Diluted Acid Hydrolysate of Olive Stones: Overliming and Biomass Fermentation. Fermentation 2025, 11, 100. https://doi.org/10.3390/fermentation11020100
Andary J, Ouaini N, Abou-Khalil R. Diluted Acid Hydrolysate of Olive Stones: Overliming and Biomass Fermentation. Fermentation. 2025; 11(2):100. https://doi.org/10.3390/fermentation11020100
Chicago/Turabian StyleAndary, Jeanne, Naïm Ouaini, and Rony Abou-Khalil. 2025. "Diluted Acid Hydrolysate of Olive Stones: Overliming and Biomass Fermentation" Fermentation 11, no. 2: 100. https://doi.org/10.3390/fermentation11020100
APA StyleAndary, J., Ouaini, N., & Abou-Khalil, R. (2025). Diluted Acid Hydrolysate of Olive Stones: Overliming and Biomass Fermentation. Fermentation, 11(2), 100. https://doi.org/10.3390/fermentation11020100

